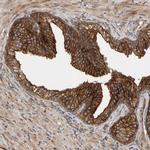
BAIAP2 Antibody in Immunohistochemistry (Paraffin) (IHC (P))

Search
Invitrogen
BAIAP2 Polyclonal Antibody
{{$productOrderCtrl.translations['antibody.pdp.commerceCard.promotion.promotions']}}
{{$productOrderCtrl.translations['antibody.pdp.commerceCard.promotion.viewpromo']}}
{{$productOrderCtrl.translations['antibody.pdp.commerceCard.promotion.promocode']}}: {{promo.promoCode}} {{promo.promoTitle}} {{promo.promoDescription}}. {{$productOrderCtrl.translations['antibody.pdp.commerceCard.promotion.learnmore']}}
产品信息
PA5-82826
种属反应
宿主/亚型
分类
类型
抗原
偶联物
形式
浓度
规格
纯化类型
保存液
内含物
保存条件
运输条件
RRID
产品详细信息
Immunogen sequence: WFPFSYTRVL DSDGSDRLHM SLQQGKSSST GNLLDKDDLA IPPPDYGAAS RAFPAQTASG FKQRPYSVAV PAFSQGLDDY GARSMSRNP
Highest antigen sequence indentity to the following orthologs: Mouse - 92%, Rat - 92%.
靶标信息
The protein encoded by this gene has been identified as a brain-specific angiogenesis inhibitor (BAI1)-binding protein. This adaptor protein links membrane bound G-proteins to cytoplasmic effector proteins. This protein functions as an insulin receptor tyrosine kinase substrate and suggests a role for insulin in the central nervous system. It also associates with a downstream effector of Rho small G proteins, which is associated with the formation of stress fibers and cytokinesis. This protein is involved in lamellipodia and filopodia formation in motile cells and may affect neuronal growth-cone guidance. This protein has also been identified as interacting with the dentatorubral-pallidoluysian atrophy gene, which is associated with an autosomal dominant neurodegenerative disease. Alternative splicing results in multiple transcript variants encoding distinct isoforms.
仅用于科研。不用于诊断过程。未经明确授权不得转售。
篇参考文献 (0)
生物信息学
蛋白别名: BAI-associated protein 2; BAI1 associated protein 2; BAR/IMD domain-containing adapter protein 2; Brain-specific angiogenesis inhibitor 1-associated protein 2; Fas ligand-associated factor 3; FLAF3; insulin receptor substrate 53; insulin receptor substrate of 53 kDa; insulin receptor substrate p53; Insulin receptor substrate p53/p58; Insulin receptor substrate protein of 53 kDa; Insulin receptor tyrosine kinase substrate protein p53; IRS-58; IRSp53; IRSp53/58; unnamed protein product; WASP and MIM like
基因别名: BAIAP2; BAP2; FLAF3; IRSP53; WAML
UniProt ID: (Human) Q9UQB8, (Rat) Q6GMN2
Entrez Gene ID: (Human) 10458, (Rat) 117542